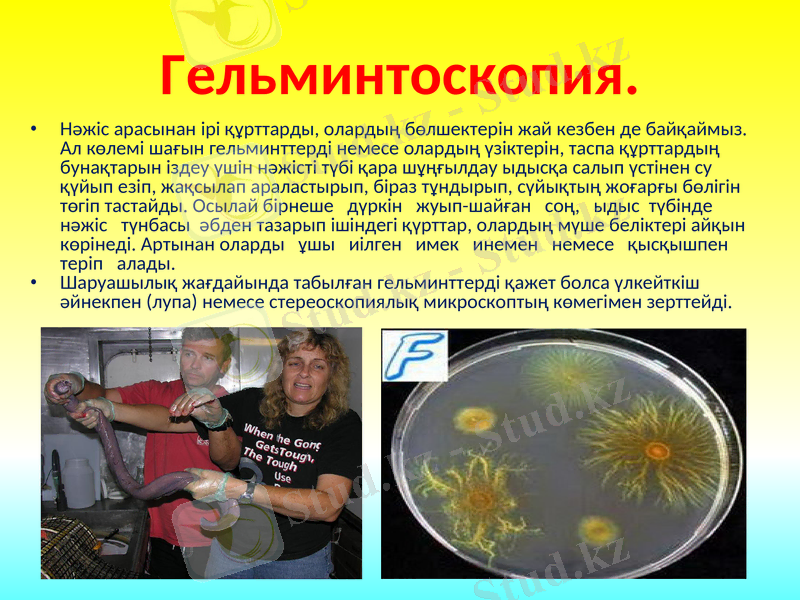
Slide 8

Гельминтология және иттердегі гельминтоздардың диагностикасы мен алдын алу шаралары



Презентация «Ит гельминтоздары»
Орындаған: Рысдаулет А., Олжабай А., Өтеулиева Г.,
Шонабаева М., Мейрамбеков І.
Тобы: АП-10-8к3
Қабылдаған: Жаңбырбаев М.
Қазақстан Республикасының Білім және Ғылым министірлігі
М. Әуезов атындағы Оңтүстік Қазақстан Мемлекеттік университеті

Гельминтология
Гельминтология көне грек сөздерінен құралған: һеlmints - құрт, 1оgоs - ілім - паразит кұрттар, яғни гельминттер және олар қоздыратын аурулар -гельминтоздар хақындағы ғылым. Гельминттерді ертеректе "глист" деп те атаған. Кейіннен академик К. И. Скрябиннің ұсынысы бойынша "глист" деген сөз "гельминт" деген атауға ауыстырылған.
Гельминтология паразит құрттардың қандай ауру тудыратынын, оның тіршілік ететін ортасын, адамға, итке, өсімдікке келтіретін алуан түрлі зиянын, емдеу жолдарын, күресу шараларын зерттейді. Бұл ғылым медициналық, итдәрігерлік және агрономиялық болып үш салаға бөлінеді. Гельминтоз дегеніміз - ішқұрттары немесе гельминттер тудыратын жұқпалы ауру. Бүл кесел адамда, жануарларда, өсімдіктерде кездеседі. Олар адам мен жануарлардың ішкі мүшелерінде (органдарында), мәселен өкпесінде, бауырында, мида, ішек-қарында жэне т. б. орналасады. Паразиттік тіршілік ететін құрттар әр түрлі болып келеді. Жалпақ құрттар қатарына трематодалар немесе сорғыш күрттар, цестодозалар немесе таспа құрттар жатады. Нематодалар жүмыр құрттар тобын құрайды. Ит мен құстың денесінде (организмде) акантоцефалар немесе тікенбасты кұрттар ұшырайды. Сондықтан, гельминтоздарды олардың қоздырғыштарының түріне байланысты трематодоздар, цестодоздар, нематодоздар және акантоцефалездар деп атайды.

Гельминттер
Гельминттер адам мен жануарлардың ішкі мүшелері жэне ұлпаларына (тканьдері), дене қуыстарына қоныс тебеді. Олар белгілі бір дене мүшесіне орнығуға бейімделген. Құрттардың көптеген түрі ас қорыту жүйелерін мекендейді. Гельминттердің басым көпшілігі ішекте күнелтеді. Мысалы, күйіс итының ащы ішегінен жүмыр жэне таспа күрттар, ал бауырынан, ұйқы безінен сорғыш құрттар(нематодалар), өкпе мен бауырға бершімектер (эхинококктар) жайғасады, шарбы-шажырқайда жылауық үшырасады. Гельминттермен жас төлден бастап ересек итке дейін зақымданады. Ішқұрт әсерінен жануардың ас қорыту, тыныс алу, тағы басқа мүшелері зардап шегеді, олардың қызмет атқару қабілеті бұзылады. Паразиттер ит денесінде қанмен, сөлмен, торшамен (клетка) қоректенеді. Организмде паразиттердің саны көбейсе, ит дертке шалдығыш, шығынға ұшырайды. Гельминтозға іліккен түліктің өнімі кемиді, басқа жұқпалы ауруға қарсы тұрарлық қабілеті төмендейді.

Гельминтоздарды анықтау
Гельминтоз ауруын дүрыс анықтап білсе, итті емдеуге жэне оны дерттен тез жазуға мүмкіншілік туады. Демек, гельминтоз түрі дэлелденген соң ғана індеттің ит арасына одан эрі таралуына жол бермеуге болады.
Диагноз қою үшін әуелі жануардың қашан кеселге шалдыққанын, дерттің қандай белгі бергенін, қандай жөм-шөп жегенін, жайылымын, суатын, мүндай дертпен түліктің бүрын-сонды ауырған-ауырмағандығын, бірден қанша бас дертке шалдыққанын сұрастырып біледі. Алдымен ауру иттің жасына, жынысына, қондылығына, азыққа тәбетіне, жүріс-түрысына назар аударады.

Гельминтоздарды тірі итті зерттеу арқылы анықтау
Тірі итке диагноз қою үшін аурудың клиникалық сырт белгілері анықталады, эпизоотологиялық деректерге сүйенеді, арнаулы зертханалық лабораториялық жөне иммунобиологиялық зерттеулер жүргізіледі. Клиникалық белгілері - гельминтоздардың клиникалық сырт белгілері кейде айқын білінеді. Ал, аурудың созылиты түрінде олар көбінесе білінбейді, көмескі (субклиникалық) немесе жасырын түрде өтеді. Көбінесе тыныс алу жүйесінің немесе асқорыту ағзалары қызметінің бүзылуы салдарынан ит демігеді, жөтеледі, іші өтеді, қоңы мен жалпы күйінің төмендеуі, сүт, ет, жүн өнімдерінің азаюы мүмкін. Жоғарыда аталған белгілер анық біліне түрса да бұған сүйеніп, ауруды анықтау қиынға соғады, өйткені мүндай белгілер басқа дерттерде де кездеседі. Р. С. Шульц (1959) айтқандай "ауруды анықтауда клиникалық белгілер шешуші емес, бағыттауыш деп қарау керек".

Арнаулы зертханалык зерттеулер.
Гельминттері жануарлардың ұлпалары мен мүшелерінде қоныс тебуіне байланысты, өздерінің өсіп-өну барысында сан алуан жолмен, ит нәжісімен, қанмен, көз жасы, басқа да денеден бөлінетін заттармен сыртқы ортаға жайылады. Мысалы, тыныс алу немесе асқорыту жүйесіндегі күрттардың жұмыртқалары және личинкалары түліктің нәжісі арқылы бөлініп шығады.

Гельминтокопрология
Ішқұрт ауруларын анықтау мақсатымен жиі қолданылатын негізгі тәсіл- гельминтокопрология, гельминтоовоскопия, яғни нэжісті зерттеу.
Нәжісті тікелей тік (көтен) ішектен алған жөн. Әдетте бұл тәсілмен тұтастай
гельминттердің өзін, не оның үзігін, бунақгарын табу (гельминтоскопия),
гельминт жұмыртқаларын іздеу (гельминтовооскопия), балаңқұрттарын ажырату (гельминтоларвоскопия) болып үш саққа жіктеледі.
Гельминтоовоскопия. Ит нэжісінен (киынан, қүитағынан не тезегінен) паразит жүмыртқаларын іздестіру. Нәжісті зерттейтін лабораториялық (зертханалық) эдістер біршама, ең бастылары төмендегідей. Нәжіс жүғындысын қарау ең қарапайым әдіс. Таза төсеніш шынының бетіне глицерин мен су қоспасының 1-2 тамшысы тамызылады. Тамшыға шыны немесе ағаштан жасалған жіңішке таяқшамен (сіріңкенің шиі де жарайды) жас нэжісінің шаиты бөлігі жақсылап араластырылады (глицерин орнына жай суды пайдалануға болады, бірақ глицерин барда жұмыртқалар айқындала түседі және олар тез арада кеппейді), содан кейін езінді сүйықтың үстін жұқа жапқыш шынымен бастырын микроскоппен қарайды. Бір жануардан 2-3 сынама нәжіс езіндісін дайындап зерттеген жөн.
Бұл қарапайым әдістің тиімділігі оны кез келген жерде қолдануға болады. Бірақ кемшілігі де жоқ емес: ол ит ішқұрттармен аз мөлшерде зақымданған кезде гельминтозды анықтау қиынға соғады. Бүл әдісті жануар денесін жаппай паразит жайлаған жағдайда пайдаланған дүрыс.
Гельминтоскопия.
Нәжіс арасынан ірі құрттарды, олардың бөлшектерін жай кезбен де байқаймыз. Ал көлемі шағын гельминттерді немесе олардың үзіктерін, таспа құрттардың бунақтарын іздеу үшін нәжісті түбі қара шұңғылдау ыдысқа салып үстінен су қүйып езіп, жақсылап араластырып, біраз тұндырып, сүйықтың жоғарғы бөлігін төгіп тастайды. Осылай бірнеше дүркін жуып-шайған соң, ыдыс түбінде нәжіс түнбасы әбден тазарып ішіндегі қүрттар, олардың мүше беліктері айқын көрінеді. Артынан оларды ұшы иілген имек инемен немесе қысқышпен теріп алады.
Шаруашылық жағдайында табылған гельминттерді қажет болса үлкейткіш әйнекпен (лупа) немесе стереоскопиялық микроскоптың көмегімен зерттейді.

Гельминтоздарды өлі итті зерттеу арқылы анықтау
- Іс жүргізу
- Автоматтандыру, Техника
- Алғашқы әскери дайындық
- Астрономия
- Ауыл шаруашылығы
- Банк ісі
- Бизнесті бағалау
- Биология
- Бухгалтерлік іс
- Валеология
- Ветеринария
- География
- Геология, Геофизика, Геодезия
- Дін
- Ет, сүт, шарап өнімдері
- Жалпы тарих
- Жер кадастрі, Жылжымайтын мүлік
- Журналистика
- Информатика
- Кеден ісі
- Маркетинг
- Математика, Геометрия
- Медицина
- Мемлекеттік басқару
- Менеджмент
- Мұнай, Газ
- Мұрағат ісі
- Мәдениеттану
- ОБЖ (Основы безопасности жизнедеятельности)
- Педагогика
- Полиграфия
- Психология
- Салық
- Саясаттану
- Сақтандыру
- Сертификаттау, стандарттау
- Социология, Демография
- Спорт
- Статистика
- Тілтану, Филология
- Тарихи тұлғалар
- Тау-кен ісі
- Транспорт
- Туризм
- Физика
- Философия
- Халықаралық қатынастар
- Химия
- Экология, Қоршаған ортаны қорғау
- Экономика
- Экономикалық география
- Электротехника
- Қазақстан тарихы
- Қаржы
- Құрылыс
- Құқық, Криминалистика
- Әдебиет
- Өнер, музыка
- Өнеркәсіп, Өндіріс
Қазақ тілінде жазылған рефераттар, курстық жұмыстар, дипломдық жұмыстар бойынша біздің қор #1 болып табылады.



Ақпарат
Қосымша
Email: info@stud.kz